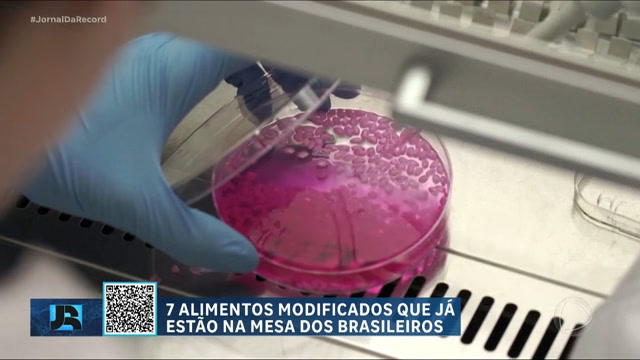

Putin insiste, sem provas, na participação da Ucrânia no atentado a casa de show em Moscou
Mikhail Metzel/Tass
O presidente russo, Vladimir Putin, afirmou que os quatro suspeitos pelo ataque que deixou 133 mortos em uma casa de shows em Moscou foram capturados enquanto fugiam para a Ucrânia. Kiev negou qualquer envolvimento com o atentado. O grupo Estado Islâmico assumiu a responsabilidade pelo ataque de sexta-feira (22) por meio de um comunicado.
Putin não mencionou o Estado Islâmico em seu discurso à nação. Kiev o acusou, assim como a outros políticos russos, de ligar falsamente a Ucrânia ao ataque para inflamar a guerra entre os países.
Autoridades de inteligência dos Estados Unidos confirmaram a reivindicação do Estado Islâmico.
“O Estado Islâmico é o único responsável por este ataque. Não houve envolvimento ucraniano algum”, disse a porta-voz do Conselho de Segurança Nacional, Adrienne Watson, em um comunicado.
ATAQUE
Os homens do Estado Islâmico invadiu a casa de show Crocus City Hall, que estava lotada à espera do show da banda de rock Piknik, e deu início a um tiroteio com pesadas armas de fogo. Eles também usaram explosivos. Ao todo, 133 pessoas morreram e mais de 140 pessoas ficaram feridas. Três crianças estão entre os mortos.
A Crocus, que fica na periferia de Moscou, ficou em chamas e dezenas de policiais e ambulâncias foram para o lugar. Teve início ainda uma perseguição para a captura dos terroristas. Onze pessoas foram presas, sendo que quatro delas têm envolvimento direto com o atentado.